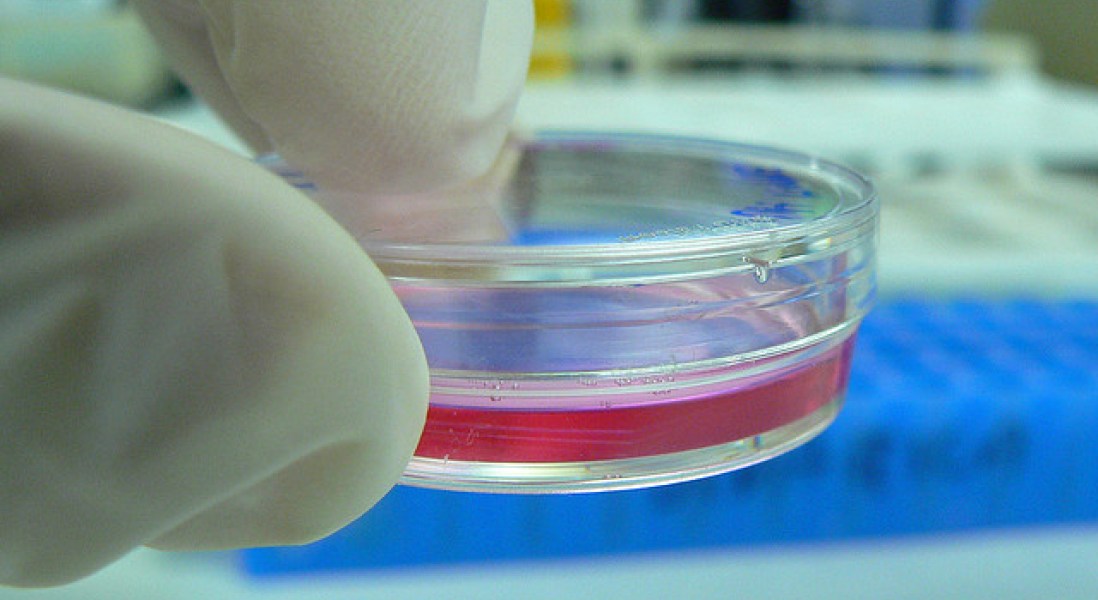
Peneliti Jepang Tumbuhkan Sel Telur Manusia di Laboratorium

All Categories
- Alat-Alat Laboratorium
- Artikel Pilihan
- Bahan Kimia
- Berita
- Bisnis
- Cancer
- Diagnostics
- Event
- Fakta Sains
- Gastrointestinal
- Gaya Hidup Sehat
- Gene Expression Research
- Genetic Research
- How To Use
- Humor Sains
- Infografik
- Jurnal
- Kerjasama
- Kesehatan
- Liputan Kegiatan
- Pengembangan Produk
- Penyakit
- Pojok Labsatu
- Republikasi post
- Research
- Sains
- Serba-Serbi
- TECH Labsatu News
- Terbaru
- Tips
- Wawancara
Tags
#LabsatuFaktaSains
Air
alatlab
alatlaboratorium
Alat laboratorium
anak
bakteri
buah
clinical
darah
diabetes
fakta sains
FDA
hewan
Ilmuwan
jantung
jerawat
jualalatlab
kanker
Kesehatan
kulit
lab
labequipment
laboratorium
laboratory
makanan
medical
Minuman
obat
otak
PCR
penelitian
penyakit
Puasa
research
riset
Sains
tanaman
teknologi
tidur
Tips
tubuh
tumbuhan
vaksin
virus